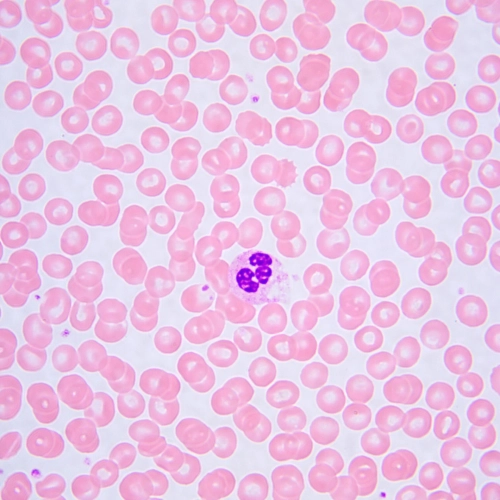
Микроскоп биологический MAGUS Bio 240T

MAGUS Bio 240T – студенческий биологический микроскоп для работы в светлом поле и исследования в проходящем свете. Модель обладает рядом особенностей: имеет кодированный револьвер, который «запоминает» настройки освещения для каждого объектива; встроенный ЖК-монитор для отображения выбранных настроек и тринокулярную визуальную насадку с отдельным тубусом под цифровую камеру.
Визуальная насадка с поворачивающимися на 360° тубусами предназначена для установки двух окуляров и цифровой камеры. Световой поток делится 100/0 или 0/100. В наборе с микроскопом поставляются два окуляра 10x/20 мм. Оптика рассчитана на бесконечность. Для удобства работы в очках окуляры комплектуются плоскими наглазниками. Они защищают оптику от царапин и повреждений, которые могут появиться при случайном столкновении. Пользователи с близорукостью и дальнозоркостью могут откорректировать резкость изображения на тубусах.
Револьвер имеет 4 гнезда под объективы и находится в положении «от пользователя» – перед исследователем расположен рабочий объектив, остальные направлены в противоположную сторону. Такое положение создает свободное пространство перед пользователем. Револьвер кодированный – яркость освещения настраивается для каждого объектива и затем при смене увеличения воссоздается. Это удобно, так как объективы пропускают разное количество света, и при повороте револьвера и смене объектива яркость освещения в окуляре изменяется. Из-за этого устают глаза, и пользователь каждый раз тратит время на подстройку освещения. «Умное» освещение поддерживает выбранную яркость и автоматически переключает ее при повороте револьвера.
Фокусировка происходит с помощью коаксиально расположенных ручек с обеих сторон микроскопа: есть грубая и тонкая настройка. Кроме того, на микроскопе есть рукоятка блокировки грубой фокусировки, которая нужна при смене объектива, и кольцо настройки хода грубой фокусировки: пользователь может настроить жесткость хода под себя. Все ручки расположены на удобной высоте: пользователь манипулирует ими, положив руки на стол, и проводит исследование, заняв удобную позу.
У предметного столика нет выдвижной зубчатой рейки по оси X. Препарат передвигается с помощью механизма на ременной передаче, перемещения происходят плавно. Препаратодержатель фиксируется на два крепежных элемента и легко демонтируется при необходимости.
Под столиком установлен конденсор Аббе. Он зафиксирован по высоте и отцентрирован по оптической оси в заводских условиях: можно не волноваться о том, чтобы случайно сдвинуть его с места. На кольцо конденсора нанесены цветные метки: по ним с помощью рукоятки конденсора можно отрегулировать апертурную диафрагму под объектив с определенным увеличением и получить контрастное изображение. Конденсор имеет числовую апертуру 1,25.
Для подсветки препарата в модели MAGUS Bio 240T используется светодиод на 3 Ватта. Можно выбрать нужную цветовую температуру в интервале от 3000 К до 7000 К. Настройки температуры легко изменяются. Светодиод рассчитан на 50 000 часов работы.
Просмотреть все выбранные настройки можно на встроенном экране: на нем отображаются яркость и цветовая температура осветителя, увеличение объектива, режим функционирования. Настройки освещения, а также рабочие режимы устанавливаются двумя ручками.
Микроскоп имеет небольшой вес и габариты и функциональный дизайн. Его можно переносить и передвигать за ручки, которые представляет собой устройство штатива. Провода и адаптер сети спрятаны на задней стенке микроскопа.
Основные особенности:
- Кодированный револьвер на 4 объектива
- «Умное» освещение, подстраивающееся под выбранный объектив
- Встроенный ЖК-дисплей наглядно представляет информацию о статусе работы микроскопа
- Тринокулярная визуальная насадка с тубусом для камеры, высота выноса зрачка регулируется вращением насадки
- Кольца диоптрийной подстройки на каждом тубусе
- Конденсор преднастроен на заводе-изготовителе, не требует центрировки и регулировки по высоте
- Апертурная диафрагма выставляется по цветной маркировке увеличений объективов на корпусе конденсора
- Оптимальный выбор для обучения студентов вузов
Комплектация:
- Штатив с источником проходящего света, механизмом фокусировки, предметным столиком, кронштейном конденсора и револьвером объективов
- Конденсор Аббе
- Тринокулярная визуальная насадка
- Объектив-планахромат, рассчитанный на бесконечность: 4x/0,10
- Объектив-планахромат, рассчитанный на бесконечность: 10x/0,25
- Объектив-планахромат, рассчитанный на бесконечность: 40x/0,65 (подпружиненный)
- Объектив-планахромат, рассчитанный на бесконечность: 100x/1,25 ми (подпружиненный)
- Окуляр 10x/20 мм с удаленным зрачком (2 шт.)
- Наглазник на окуляр (2 шт.)
- Переходник под крепление C-mount для работы с камерой
- Светофильтр
- Адаптер питания и сетевой шнур питания для микроскопа
- Пылезащитный чехол
- Инструкция по эксплуатации и гарантийный талон
Поставляются по дополнительному заказу:
- Цифровая камера
- Калибровочный слайд
- Монитор
Характеристики
| Бренд | MAGUS (Магус) |
| Гарантия | 5 лет |
| EAN | 5905555019437 |
| Размер упаковки (ДxШxВ) | 45x30x65 см |
| Вес упаковки | 9.8 кг |
| Тип | биологические, световые/оптические |
| Тип насадки | тринокулярная |
| Насадка | Gemel (Зидентопф с вращением тубусов на 360°), деление светового потока 0/100, 100/0 |
| Угол наклона окулярной насадки | 30° |
| Диапазон увеличения, крат | 40 — 1000 |
| Диаметр окулярной трубки, мм | 23.2 |
| Окуляры | 10x/20 мм, удаленный зрачок |
| Объективы | планахроматические, скорректированные на бесконечность: 4x/0,10; 10x/0,25; 40xs/0,65; 100xs/1,25 ми; парфокальная высота 45 мм |
| Револьверное устройство | на 4 объектива, кодированное |
| Межзрачковое расстояние, мм | 47 — 75 |
| Предметный столик, мм | 180x130 |
| Диапазон перемещения предметного столика, мм | 74/30 |
| Характеристики предметного столика | двухкоординатный механический, без выдвижной рейки |
| Возможность диоптрийной коррекции, D | ±5, на обоих тубусах |
| Возможность диоптрийной коррекции | ✓ |
| Конденсор | конденсор Аббе NA 1,25 с регулируемой апертурной диафрагмой и цветовой маркировкой увеличения объективов |
| Диафрагма | регулируемая апертурная |
| Фокусировка | коаксиальная, грубая (17 мм, 37,7 мм/оборот, с механизмами блокировки и регулировки жесткости) и тонкая (0,002 мм, 0,2 мм/оборот) |
| Подсветка | светодиодная |
| Регулировка яркости | ✓ |
| Источник питания | 100–240 В, 50/60 Гц, сеть переменного тока, адаптер питания AC/DC вынесен и крепится в гнезде сзади штатива |
| Тип лампы подсветки | светодиод 3 Вт, с регулировкой цветовой температуры (3000–7000 К) |
| Светофильтры | есть |
| Дополнительно | авторегулировка яркости освещения при смене объектива, отображение статуса на экране, режим сна, эко-режим |
| Уровень пользователя | для опытных, для профессионалов |
| Уровень сложности сборки и настройки | сложно |
| Назначение | лабораторные/медицинские |
| Расположение подсветки | нижняя |
| Метод исследования | светлое поле |
| Чехол/кейс/сумка в комплекте | чехол пылезащитный |
- Штатив с источником проходящего света, механизмом фокусировки, предметным столиком, кронштейном конденсора и револьвером объективов
- Конденсор Аббе
- Бинокулярная визуальная насадка
- Объектив-планахромат, рассчитанный на бесконечность: 4x/0,10
- Объектив-планахромат, рассчитанный на бесконечность: 10x/0,25
- Объектив-планахромат, рассчитанный на бесконечность: 40x/0,65 (подпружиненный)
- Объектив-планахромат, рассчитанный на бесконечность: 100x/1,25 ми (подпружиненный)
- Окуляр 10x/20 мм с удаленным зрачком (2 шт.)
- Наглазник на окуляр (2 шт.)
- Светофильтр
- Адаптер питания и сетевой шнур питания для микроскопа
- Пылезащитный чехол
- Инструкция по эксплуатации и гарантийный талон
Поставляются по дополнительному заказу:
- Цифровая камера
- Калибровочный слайд
- Адаптер C-mount
- Монитор